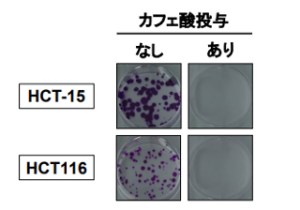

このタイトルを見て一瞬ハテナ?と思いませんか? 自分だけかもしれませんが、じゅくじゅくした傷口の水分を水飴の水が吸い込む。同じ水同士で浸透圧が作用するのか?と早合点した。謎解きは後半にするとして、まずは文献を見てみよう。
東北大と東京薬科大が2026.03.26に発表。
「水あめの浸透圧を利用した新たな創傷被覆材がキズを治りやすくするメカニズムを解明-「治す力を高める」創傷被覆材でキズに苦しむ患者を救う!-」
ポイントを引用すると
水あめによる浸透圧を利用した新しい創傷被覆材に治癒効果があるメカニズムを、マウスを用いて解明しました。
キズの治りを早めるカギは、本創傷被覆材の増殖因子 等の「治りに必要な成分を逃さない」作用であることを明らかにしました。
本創傷被覆材が持つ機能を活用した「患者の治す力を高める(免疫細胞を活性化する 」創傷ケアは、難治性創傷(治りにくいキズ)に苦しむ患者を救う新たな解決策となることが期待されます。


効果がわかったところで冒頭の疑問「なぜ水同士なのに浸透圧が発生するのか」
について考察する。まず水飴は主に「でん粉」を酸や酵素で分解(糖化)して作られる。 主原料はでん粉(コーンスターチ、甘薯でん粉、馬鈴薯でん粉など)。糖化剤:は酸、酵素、または大麦麦芽 (向後スターチ社情報)で、一般的な水分20~25%とのこと。
だが、この水分に限界まで糖分(ブドウ糖や麦芽糖)が溶け込んだ超高濃度の液体で水分は糖と水素結合などで自由に動ける水ではないと考えられる。むしろ じゅくじゅくした傷に存在する水分濃度の方が高く、水飴の水分濃度が低い。こう考えると傷口から水分が水飴に浸透圧で移行するのが整理できる。この浸透圧が高いので傷口に存在する菌の細胞の中の水分まで吸収する。
現在病院で処方される白糖製剤は精製された白糖(約70%)とポビドンヨード(殺菌剤)を練り合わせたもの。糖の浸透圧で傷を洗浄し、ヨードで菌を叩くというハイブリッドな仕組み。ご家庭にある砂糖では効果的ではないとの説もあるのだが、この何故?を調べるうちに、九州や東北では砂糖を傷口に塗ることは昔からの知恵であったと知った。科学の進歩が経験を掘り起こし光をあてる。実に面白い。